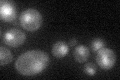
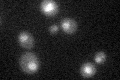

View description
Ubiquitin-conjugating enzyme (E4), elongates polyubiquitin chains on substrate proteins; works in opposition to Ubp6p polyubiquitin-shortening activity; required for retrograde transport of misfolded proteins into cytoplasm during ERAD
Localization:
Intensity:
Fold change:
Significance:
-
C’ GFP library in SD
nucleus28.49 -
N' NOP1pr-GFP in SD

mitochondria77.9866 -
N' TEF2pr-mCherry in SD

missing0 -
N' NATIVEpr-GFP in SD

punctate,nucleus22.5158 -
N' TEF2pr-VC and Cyto-VN in SD

#N/A0 -
C’ GFP library in SD+DTT

nucleus33.471.17No -
C’ GFP library in SD+H2O2

nucleus33.521.17No -
C’ GFP library in Starvation Media
nucleus34.071.19No -
C’ GFP library on the background of Pup2-DaMP

nucleus -
C’ GFP library on the background of CCT mutant

nucleus27.67580.971147No
